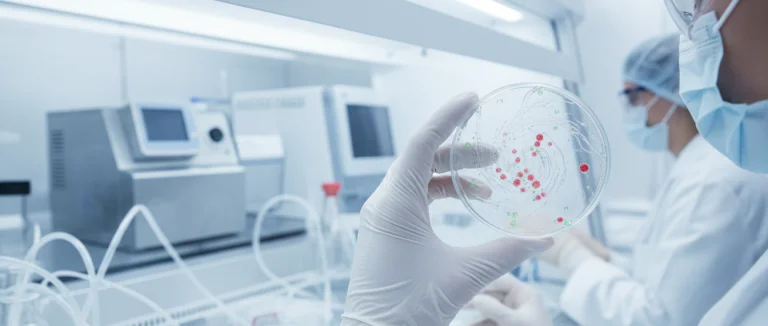
Лаборатория по работе со стволовыми клетками

Плюсы и Минусы Терапии Стволовыми Клетками | Лив Хоспитал
-
Плюсы терапии стволовыми клетками
-
Минусы и потенциальные риски терапии стволовыми клетками
-
Ключевые типы стволовых клеток и их применение
-
Критерии отбора пациентов и процесс лечения в Лив Хоспитал
-
Сравнение терапии стволовыми клетками с традиционными методами лечения
-
Почему выбирают Лив Хоспитал
Терапия стволовыми клетками привлекает всё больше внимания пациентов, ищущих инновационные решения для сложных заболеваний. В этой статье мы подробно рассмотрим плюсы и минусы терапии стволовыми клетками, проанализируем, какие риски и выгоды связаны с этим методом, а также расскажем, как международный центр Лив Хоспитал обеспечивает высокий уровень безопасности и эффективности.
По данным международных исследований, более 210 000 пациентов ежегодно обращаются к стволовым клеткам в попытке ускорить восстановление тканей после травм, а также для лечения онкологических и неврологических заболеваний. Однако, несмотря на впечатляющие результаты, существуют и существенные ограничения, которые важно учитывать перед принятием решения о лечении.
Мы разберём, какие типы стволовых клеток применяются в клинической практике, какие показания являются наиболее обоснованными, а также какие осложнения могут возникнуть. Эта информация поможет вам сформировать объективное представление о том, подходит ли вам данный метод и насколько он соответствует вашим ожиданиям.
Ниже представлены основные аспекты, которые стоит учитывать при оценке терапии стволовыми клетками: научные доказательства эффективности, потенциальные побочные эффекты, стоимость и доступность процедур, а также особенности организации лечения в международных клиниках.
Плюсы терапии стволовыми клетками
Терапия стволовыми клетками обладает рядом преимуществ, которые делают её привлекательной для пациентов с различными заболеваниями. Ниже перечислены ключевые плюсы, подтверждённые клиническими исследованиями и практикой ведущих медицинских центров.
- Способность к регенерации повреждённых тканей – стволовые клетки могут дифференцироваться в клетки различных типов, способствуя восстановлению органов.
- Минимальная инвазивность – большинство процедур проводятся через инъекции или инфузии, что уменьшает травматизм по сравнению с хирургическими вмешательствами.
- Снижение риска отторжения – при использовании аутологичных (из собственного организма) стволовых клеток риск иммунного отклика практически отсутствует.
- Потенциал для лечения широкого спектра заболеваний: от остеоартроза и сердечной недостаточности до рассеянного склероза и некоторых видов рака.
- Ускоренное заживление после травм и операций, что сокращает реабилитационный период.
Важно отметить, что терапия стволовыми клетками часто комбинируется с другими методами, такими как физиотерапия, медикаментозное лечение и биологические препараты, усиливая общий терапевтический эффект.
Кроме того, в последние годы наблюдается рост количества клинических испытаний, подтверждающих эффективность мезенхимальных стволовых клеток (MSC) в регенерации хрящевой ткани и улучшении функции суставов. Это открывает новые возможности для пациентов, страдающих от хронических болей и ограниченной подвижности.

Минусы и потенциальные риски терапии стволовыми клетками
Несмотря на очевидные преимущества, у терапии стволовыми клетками есть и существенные недостатки, которые следует учитывать. Ниже представлены основные риски и ограничения, часто обсуждаемые в медицинском сообществе.
- Ограниченная доказательная база – для многих показаний пока нет достаточного количества рандомизированных контролируемых исследований.
- Возможность нежелательной дифференциации – стволовые клетки могут образовывать ткани, не соответствующие целевому органу, что приводит к образованию кисты или опухоли.
- Риск инфекции – процедуры, связанные с забором костного мозга или адипоцитарных тканей, требуют стерильных условий, иначе возможна бактериальная контаминация.
- Высокая стоимость лечения – в большинстве стран терапия стволовыми клетками не покрывается страховкой и может стоить от нескольких тысяч до десятков тысяч долларов.
- Отсутствие единых регуляторных стандартов – в разных странах различаются требования к качеству и безопасности клеточных препаратов.
Кроме того, некоторые пациенты могут испытывать аллергические реакции на вспомогательные вещества, используемые в процессе культивирования клеток. Важно, чтобы перед началом терапии был проведён тщательный скрининг, включающий анализы крови, оценку иммунного статуса и обсуждение истории заболеваний.
В случае применения терапии стволовыми клетками в онкологии необходимо учитывать возможность стимулирования роста опухолевых клеток, если клетки не были полностью очищены от опухолевых маркеров.
Ключевые типы стволовых клеток и их применение
Существует несколько основных категорий стволовых клеток, каждая из которых обладает уникальными свойствами и применяется в разных клинических сценариях.
Эмбриональные стволовые клетки (ESC)
Эмбриональные стволовые клетки способны дифференцироваться во все типы клеток организма, что делает их потенциально мощным инструментом для регенерации. Однако их использование ограничено этическими и правовыми нормами, а также высоким риском опухолевой трансформации.
Мезенхимальные стволовые клетки (MSC)
Мезенхимальные стволовые клетки, получаемые из костного мозга, жировой ткани или пуповинной крови, широко применяются в ортопедии, кардиологии и неврологии. Они обладают иммуносупрессивными свойствами, способствуют заживлению и уменьшают воспаление.
Гематопоэтические стволовые клетки (HSC)
Гематопоэтические стволовые клетки находятся в костном мозге и отвечают за формирование всех кровяных линий. Трансплантация HSC (костный мозг) является стандартом лечения многих гемато-онкологических заболеваний, включая лейкемию.
В Лив Хоспитал применяется проверенный протокол культивирования MSC, позволяющий достичь высокой жизнеспособности клеток и минимизировать риск контаминации.
- Источник: костный мозг – наиболее часто используемый для получения MSC.
- Источник: адипоцитарная ткань – менее инвазивный метод забора, подходящий для аутологичных процедур.
- Источник: пуповинная кровь – идеален для неинвазивных процедур у новорождённых и детей.
Критерии отбора пациентов и процесс лечения в Лив Хоспитал
Прежде чем приступить к терапии стволовыми клетками, необходимо пройти комплексный отбор, который включает в себя медицинскую оценку, лабораторные исследования и согласование целей лечения.
- Первичная консультация – врач‑специалист оценивает анамнез, текущие симптомы и ожидаемые результаты.
- Лабораторный скрининг – включает общий анализ крови, биохимический профиль, иммунологический статус и тесты на наличие инфекций.
- Определение типа клеток – выбирается наиболее подходящий тип стволовых клеток (MSC, HSC и т.д.) в зависимости от показаний.
- Подготовка клетки – в лаборатории происходит изоляция, очистка и культивирование клеток до необходимого количества.
- Введение клеток – проводится под контролем ультразвука или с помощью эндоскопических методов, в зависимости от локализации поражения.
- Постпроцедурный мониторинг – пациенты находятся под наблюдением в течение 24‑48 часов, после чего назначаются контрольные визиты.
Лив Хоспитал гарантирует, что каждый этап проходит в соответствии с международными протоколами JCI, а все клетки проходят строгий контроль качества, включая тесты на стерильность и генетическую стабильность.
Сравнение терапии стволовыми клетками с традиционными методами лечения
Для более полного понимания преимуществ и ограничений терапии стволовыми клетками полезно сравнить её с традиционными подходами, такими как медикаментозная терапия, хирургическое вмешательство и лучевая терапия.
| Параметр | Терапия стволовыми клетками | Традиционные методы |
|---|---|---|
| Инвазивность | Минимальная (инъекции, инфузии) | Средняя‑высокая (операции, лучевая терапия) |
| Время восстановления | От нескольких дней до недели | От нескольких недель до месяцев |
| Риск осложнений | Низкий, но возможны инфекции и реактивные реакции | Высокий риск осложнений, включая кровотечения и инфекцию |
| Долгосрочная эффективность | Продолжается изучать, хорошие результаты в регенерации тканей | Зависит от заболевания; часто требуется повторное лечение |
| Стоимость | Высокая, часто не покрывается страховкой | Разнообразна, но часто более доступна в рамках государственных программ |
Как видно из таблицы, терапия стволовыми клетками предлагает уникальные возможности регенерации при относительно низкой инвазивности, однако её стоимость и ограниченная доказательная база остаются существенными барьерами для широкого применения.
Почему выбирают Лив Хоспитал
Лив Хоспитал – это аккредитованная JCI группа частных больниц в Стамбуле, специализирующаяся на международных пациентах. Мы предлагаем комплексный подход к терапии стволовыми клетками, включающий полное сопровождение от первой консультации до постпроцедурного наблюдения.
Наши преимущества:
- Квалифицированные специалисты с многолетним опытом в регенеративной медицине.
- Современные лаборатории, где клетки проходят строгий контроль качества.
- Индивидуальное сопровождение иностранных пациентов: переводчики, транспорт, помощь с размещением.
- Полный пакет медицинских услуг, включающий диагностику, реабилитацию и психологическую поддержку.
Выбирая Лив Хоспитал, вы получаете уверенность в том, что лечение будет проведено в соответствии с международными стандартами, а каждый шаг процесса будет прозрачным и безопасным.
Готовы узнать, подходит ли вам терапия стволовыми клетками? Запишитесь на бесплатную онлайн‑консультацию с нашими специалистами уже сегодня. Мы поможем подобрать оптимальный план лечения и организуем весь процесс, чтобы вы могли сосредоточиться на выздоровлении.
Часто задаваемые вопросы
Терапия стволовыми клетками обладает способностью дифференцироваться в различные типы клеток, что позволяет восстанавливать повреждённые органы и ткани. Процедуры обычно проводятся через инъекции или инфузии, что делает их менее травматичными по сравнению с хирургией. При использовании аутологичных клеток (из собственного организма) практически отсутствует иммунный отклик, что уменьшает риск отторжения. Кроме того, стволовые клетки могут оказывать иммуносупрессивное действие, снижая воспаление и ускоряя заживление после травм и операций. Наконец, они часто комбинируются с другими методами лечения, усиливая общий терапевтический эффект.
Несмотря на преимущества, терапия стволовыми клетками имеет несколько существенных недостатков. Для многих показаний отсутствуют достаточные рандомизированные контролируемые исследования, что ограничивает доказательность эффективности. Существует риск нежелательной дифференциации, когда клетки образуют ткани, не соответствующие целевому органу, что может привести к кистам или опухолям. Процедуры забора и культивирования клеток требуют строгих стерильных условий; иначе возможна бактериальная контаминация. Стоимость лечения часто высока и не покрывается страховкой, а отсутствие единых международных регуляторных стандартов усложняет контроль качества. Кроме того, у некоторых пациентов могут возникнуть аллергические реакции на вспомогательные вещества, используемые в процессе культивирования.
Эмбриональные стволовые клетки (ESC) способны дифференцироваться во все типы клеток организма, но их использование ограничено этическими и правовыми нормами, а также высоким риском опухолевой трансформации. Мезенхимальные стволовые клетки (MSC) получают из костного мозга, жировой ткани или пуповинной крови; они широко применяются в ортопедии, кардиологии и неврологии благодаря иммуносупрессивным свойствам и способности ускорять заживление. Гематопоэтические стволовые клетки (HSC) находятся в костном мозге и отвечают за формирование всех кровяных линий; их трансплантация является стандартом лечения многих гемато‑онкологических заболеваний, таких как лейкемия. В Лив Хоспитал используется проверенный протокол культивирования MSC, обеспечивающий высокую жизнеспособность и минимальный риск контаминации.
Перед началом терапии пациент проходит первичную консультацию, где врач оценивает анамнез и ожидаемые результаты. Затем проводится лабораторный скрининг (общий анализ крови, биохимический профиль, иммунологический статус, тесты на инфекции). На основе показаний выбирается тип стволовых клеток – MSC, HSC или иной. В лаборатории клетки изолируют, очищают и культивируют до необходимого количества, проверяя стерильность и генетическую стабильность. Введение клеток происходит под контролем ультразвука или эндоскопически, в зависимости от локализации поражения. После процедуры пациент находится под наблюдением 24‑48 часов, затем назначаются контрольные визиты. Все этапы соответствуют международным протоколам JCI.
Терапия стволовыми клетками обычно проводится через инъекции или инфузии, что делает её менее травматичной по сравнению с хирургическими вмешательствами или лучевой терапией. Время восстановления после процедуры может составлять от нескольких дней до недели, тогда как после операции – от нескольких недель до месяцев. Риск осложнений ниже, однако возможны инфекции и реактивные реакции. Долгосрочная эффективность пока изучается, но уже есть хорошие результаты в регенерации тканей. Стоимость терапии обычно выше и часто не покрывается страховкой, тогда как традиционные методы могут быть более доступными в рамках государственных программ. Выбор метода зависит от конкретного заболевания, финансовых возможностей пациента и наличия доказательной базы.
* Содержимое нашего сайта предназначено только для информационных целей. Обязательно обратитесь к врачу для диагностики и лечения. В содержание страницы не включены элементы, содержащие информацию о терапевтических медицинских услугах в Лив Госпитале.













